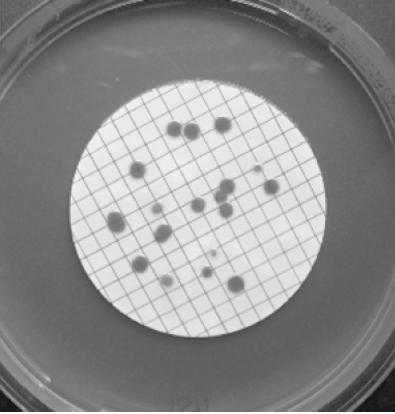
Membrane filtration technique - Membrane filtration technique

Enumeration of microorganisms is especially important in dairy microbiology, food microbiology, pharmaceutical microbiology, and water microbiology.
The number of microorganisms in a culture, sample, or specimen is measured to assess the levels of microbial contamination in raw material or manufactured products (such as medicine). Enumeration is also done to evaluate the effects of antimicrobial agents or the decontamination processes.
Methods for counting microorganisms
In some cases, it is necessary to know the total number of (both living and dead) microorganisms. For example, in endotoxin (pyrogen) testing, dead and alive cells induce fever when injected into the body. However, in many cases, the number or concentration of living cells is required.
| Viable counts (traditional method) | Total counts (traditional method) | Rapid methods (indirect viable counts) |
|---|---|---|
| Pour plate method | Direct microscopic counting (using Helber or haemocytometer counting chambers) | Epifluorescence often coupled with image analysis |
| Surface spread or spread plate method | Turbidity methods | ATP testing |
| Membrane filter method | Dry weight determination | Impedance method |
| MPN Method | Nitrogen, protein, or nucleic acid determinations | Manometric methods |
Traditional and rapid methods of enumerating microorganisms
Total Count Technique
Total count is a counting procedure enumerating both living and dead cells.
Direct Microscopic count
Direct microscopic counts are possible using special slides known as counting chambers, consisting of a ruled slide and a coverslip. It is constructed so that the coverslip, slide, and ruled lines delimit a known volume. The number of bacteria in a small known volume is microscopically counted, and the number of bacteria in the larger original sample is determined by extrapolation. Dead cells cannot be distinguished from living ones. Only dense suspensions can be counted.

Bacteria can be counted efficiently and accurately with the Petroff-Hausser counting chamber. This is a special slide accurately ruled into squares that are 1/400 mm² in the area; a glass coverslip rests 1/50 mm above the slide so that the volume over a square is 1/20,000 mm² i.e. 1/20, 000, 000 cm². If, for example, an average of five bacteria is present in each ruled square, there are 5 x 20,000,000 or 10^8 bacteria per milliliter. A suspension of unstained bacteria can be counted in the chamber using a phase-contrast microscope.
**The formula used for the direct microscopic count is:**The number of bacteria per cc = The average numbers of bacteria per large double-lined square X The dilution factors of the large square (1,250,000) X The dilution factor of any dilutions made before placing the sample in the counting chamber, e.g., mixing the bacteria with dye
Advantages of Direct Microscopic count
- Rapid, simple, and easy method requiring minimum equipment.
- Morphology of the bacteria can be observed as they are counted.
- Very dense suspensions can be counted if they are diluted appropriately.
Limitations of Direct Microscopic count
- Dead cells are not distinguished from living cells.
- Small cells are difficult to see under the microscope, and some cells are probably missed.
- Precision is difficult to achieve
- A phase-contrast microscope is required when the sample is not stained.
- The method is not usually suitable for cell suspensions of low density i.e., < 107 Cells per ml, but samples can be concentrated by centrifugation or filtration to increase sensitivity.
Turbidity Method
Turbidity measurements are the most common means of estimating the total number of bacteria present in a sample. Measuring the turbidity using a spectrophotometeror colorimeter and reading the concentration from a calibration plot is a simple means of standardizing cell suspensions for inocula in antibiotic assays or other tests of antimicrobial chemicals.
Viable Count Technique
Viable countrecords living cells alone. The viable count is more common than the total count. A viable cell is defined as one that can divide and form offspring. Most pharmacopeias and regulatory agencies use a total viable count (TVC), i.e., a viable count that records all the different species or types of microorganisms (e.g., bacteria plus fungi). present in the sample
The usual way to perform a viable count is to determine the number of cells in the sample capable of forming colonies on a suitable agar medium. For this reason, the **viable count is often called the plate count or colony count.**This method is used to enumerate bacteria in milk, water, foods, soils, cultures, etc., and the number of bacteria is expressed as **colony-forming units (CFU)**per ml.

With both the spread plate and pour plate method, it is essential that the number of colonies developing on the plates not be too many because, on crowded plates, some cells may not form colonies, and some colonies may fuse, leading to erroneous measurements. It is also essential that the number of colonies not be too few, or the statistical significance of the calculated count will be low. The usual practice, which is the most valid statistically, is to count colonies only on plates that have between 30 and 300 colonies.
The number of bacteria in a given sample may usually be too many to be counted (TMTC). The sample must be diluted to obtain the appropriate colony number so that visible isolated colonies appear. The number of colonies can be used to measure the number of viable cells in that known dilution. Several 10-fold dilutions of the sample are commonly used. Usually, serial dilutions are employed to reach the final desired dilution.
However, if the organism typically forms multiple cell arrangements, such as chains, the colony-forming unit may consist of a chain of bacteria rather than a single bacterium. In addition, some of the bacteria may be clumped together. The development of one colony can occur even when the cells are in aggregates. i.e., cocci in clusters (staphylococci), chains (streptococci), or pairs (diplococci). In such cases, the resulting counts will be lower than the number of individual cells.
**Each colony that can be counted is called a colony-forming unit (CFU).**By extrapolation, this number can be used to calculate the number of CFUs in the original sample rather than the number of bacteria per milliliter. The assumption made in this type of counting procedure is that each viable cell can yield one colony. There are two ways of performing a plate count: the spread plate method and the pour plate method.
Generally, one wants to determine the number of CFUs per milliliter (ml) sample. To find this, the number of colonies (on a plate having 30-300 colonies) is multiplied by the number of times the original ml of bacteria was diluted (the dilution factor of the plate counted).
For example, suppose a plate containing a 1/1,000,000 dilution of the original ml of the sample shows 150 colonies. In that case, the number of CFUs per ml in the original sample is found by multiplying 150 x 1,000,000, as shown in the formula below:
The number of CFUs per ml of sample = The number of colonies (30-300 plate) X The dilution factor of the plate counted
In the case of the example above 150 x 1,000,000 = 150,000,000 CFUs per ml
Advantage of viable count method
This method is used routinely and with satisfactory results for estimating bacterial populations in milk, water, foods, and many other materials.
- It is easy to perform and can be adapted to measuring populations of any magnitude.
- It is a sensitive method(theoretically, a single viable cell can be detected). For example, if a specimen contains as few as one bacterium per ml, one colony should develop upon the plating of 1 ml.
- It allows for inspection and identification of the organism counted.
Limitation of viable count technique
- Only living cells develop colonies
- Clumps or chains of cells develop into a single colony
- Colonies develop only from those organisms for which the cultural conditions are suitable for growth.
Pour Plate Technique
A pour plate is a method of melted agar inoculation followed by petri dish incubation. The known volume (usually 0.1-1.0 ml) of culture is pipetted into a sterile Petri plate; melted agar medium is then added and mixed well by gently swirling the plate on the tabletop. Because the sample is mixed with the molten agar medium, a larger volume can be used than the spread plate. However, with the pour plate method, the organism to be counted must be able to briefly withstand the temperature of melted agar, 45°C. After solidification of the gel, the plate is inverted and incubated at 37°C for 24-48 hours.

Pour plates are useful for quantifying microorganisms that grow in a solid medium. Because the “pour plate” embeds colonies in agar, it can supply a sufficiently oxygen-deficient environment that can allow the growth and quantification of microaerophiles.
Spread Plate Technique
Spread plate technique is one of the methods of quantifying microorganisms on a solid medium. With the spread plate method, a volume of an appropriately diluted culture, usually no greater than 0.1 ml, is spread over the surface of an agar plate using a sterile glass spreader. The plate is then incubated until the colonies appear, and the number of colonies is counted.

An advantage of spreading a plate over the pour plate method is that cultures are never exposed to 45°C (i.e., melted agar temperatures).Note: The surface of the plate must be dry so that the spread liquid soaks in. Volume greater than 0.1ml is rarely used because the excess liquid does not soak in and may cause the colonies to coalesce as they form, making them difficult to count.
Membrane Filter Method
A large known volume of sample is passed through the membrane, and then the membrane is placed, without inversion, on the agar surface. Nutrients diffuse through the membrane and allow retained cells to grow into colonies. Membrane filtration detects lower concentrations of microorganisms than other methods, but it can not be used to test microbial loads of viscous samples.
Find more about membrane filtration techniques in this post.
Most Probable Number (MPN) Method
Most probable number (MPN) counts may be used when the anticipated count is relatively low, i.e., from <1 to 100 microorganisms per ml. The procedure involves inoculating multiple tubes of culture medium, usually three or five, with three different volumes of the sample (0.1 ml, 0.001 ml, and 0.001 ml).

The proportions of positive tubes are recorded for each sample volume, and the results are compared with standard tables showing the MPN of organisms per ml of the original sample. MPN technique is commonly used in the water, food, and dairy industries.
Find more about MPN technique in this post.
Rapid Methods
Rapid methods enumerate viable microorganisms, usually bacteria and yeasts, within a matter of hours and eliminate traditional methods’ 24-48 hour (or longer) incubation periods. They employ various means for indirect detection of living cells.
Rapid methods are fast, readily automated, and eliminate the need for numerous Petri dishes and incubators but may require the purchase of expensive equipment. Detection limits may vary based on the equipment types, test types, and manufacturers.
Epifluorescent Technique
It uses fluorescent dyes that either exhibit different colors in living and dead cells (e.g., acridine orange) or appear colorless outside the cell but become fluorescent when absorbed and subjected to cellular metabolism (e.g., fluorescein diacetate).
ATP Testing
Living cells generate adenosine triphosphate (ATP) that can readily be detected by enzyme assays, e.g., luciferin emits light when exposed to firefly luciferase in the presence of ATP; light emission can be measured and related to bacterial concentration.
Impedance Technique
The resistance, capacitance, or impedance of a culture medium changes due to bacterial or yeast growth and metabolism, and these electrical properties vary in proportion to cell concentration.
Manometric Technique
Manometric techniques are appropriate for monitoring the growth of organisms that consume or produce significant quantities of gas during their metabolism, e.g., yeasts or molds producing carbon dioxide from fermentation.
References
- Buss da Silva, N., Mattar Carciofi, B. A., Ellouze, M., & Baranyi, J. (2019). Optimization of turbidity experiments to estimate the probability of growth for individual bacterial cells. Food microbiology, 83, 109–112. https://doi.org/10.1016/j.fm.2019.05.003
- Clais, S., Boulet, G., Van Kerckhoven, M., Lanckacker, E., Delputte, P., Maes, L., & Cos, P. (2015). Comparison of viable plate count, turbidity measurement and real-time PCR for quantification of Porphyromonas gingivalis. Letters in applied microbiology, 60(1), 79–84. https://doi.org/10.1111/lam.12341